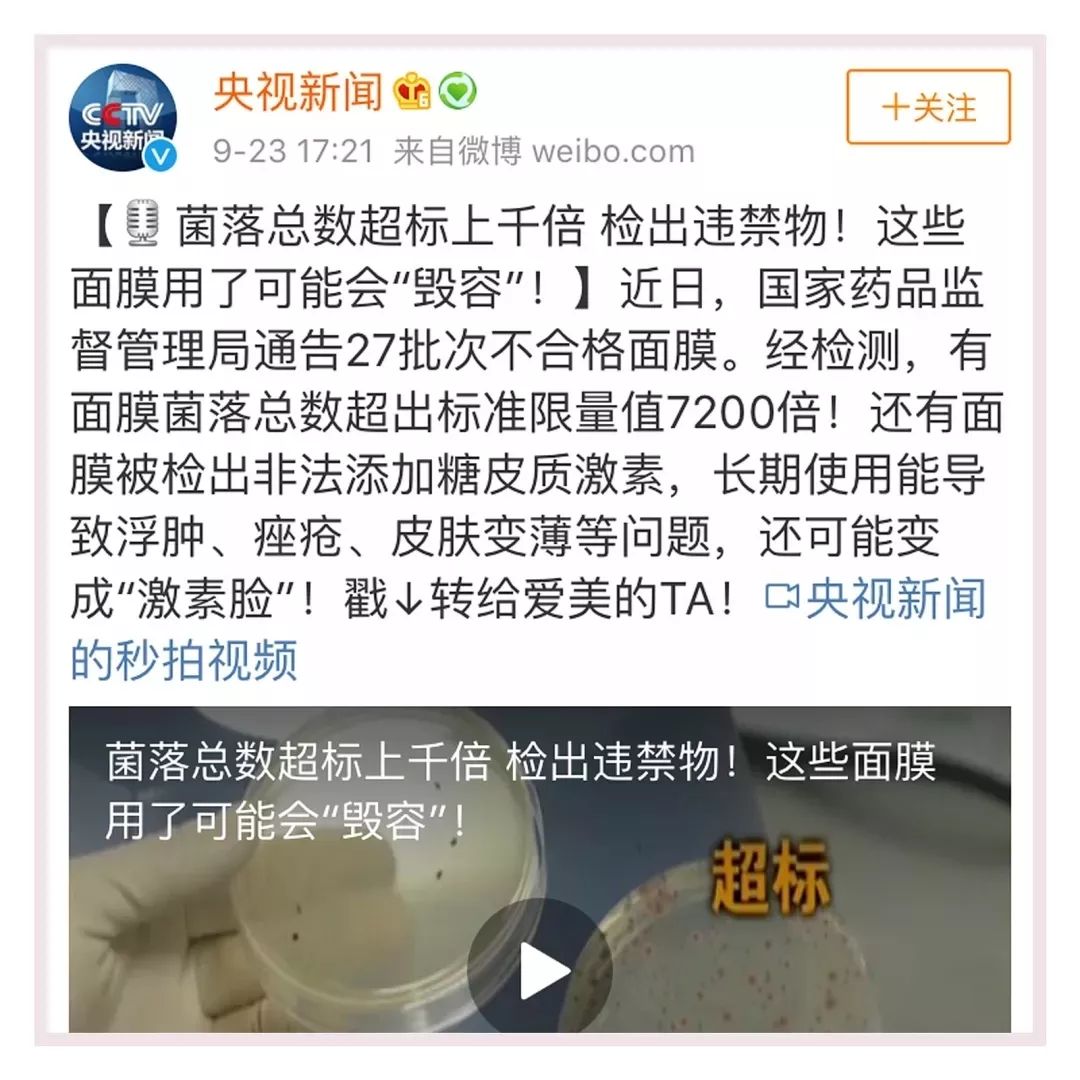

点击上方绿色按钮⊙即可收听本期音频
焦点中的婚姻,都是流言蜚语。哪怕是霍建华婚礼现场没有微笑,都被说成是“被结婚”。事实真是如此吗?一个女人最大的幸福, 莫过于拥有幸福的家庭。林心如诞下一女儿后,高情商的霍建华直接给女儿取名为“霍晓茹”,来表达对妻子林心如的浓情蜜意。

产后的林心如被霍建华照顾的很好,满脸笑容羡煞旁人!而且上头条新闻频率也非常的高。网友惊奇的感叹:这颜值比22年前出演《还珠格格》时还要美啊!除了好奇林心如的御夫之术外,小编更加好奇她是怎么保养的!

在一次商业活动中,心如透露:养儿不能防老,面膜才能防老。
对于精致的女人来说,
面膜更是续命一般的存在。
女明星一年敷700张面膜,
40岁看起来还像20出头,
足以证明面膜有多重要了!

01
敷面膜真的能防老吗?
经常有关注新闻的小伙伴应该知道,时不时会爆出国内一些不合格的面膜,你用过吗?这些不合格的面膜用久了之后会变成激素脸。每天和你“朝夕相处”的面膜,可能真没想象中那么爱你。你以为它能补水美白灭皱纹,殊不知,敷错面膜,会烂脸。所以不得不提高警惕。
之前,央视就点名批评了27款“毁容”面膜▼
不敷面膜吧,又出现一些面部干燥、卡粉、过敏的情况,尤其是在炎热的夏季。

想要找到一款好面膜真不容易啊!眼尖的小编发现,最近一款无添加面膜风靡了半个娱乐圈,女明星录节目都带着它。
冯女郎之一“钟楚曦”在综艺节目中大胆素颜敷面膜,皮肤白净,被同伴问及保养秘诀的时候,她表示每天早晚一片“黛汐魅素颜珍珠面膜”;就算是坐飞机也一定要用这款面膜补水。

包文婧在参加《妻子的旅行》时,就给大家安利过自己在用的无添加面膜,并大赞其“一片多效,补水、亮白、紧致”!

在一次突袭翻包中,眼尖的小编发现,“少女辣妈”颖儿也是早晚使用和林心如、林志颖、包文倩一样的同款面膜,还强调敏感肌也能用。

是什么样的一款面膜,让明星大大追捧呢?小编仔细上网查了一下,才了解到这款面膜叫“黛汐魅素颜面膜”,这款是一款安全度达到食品级的面膜。不同于功效单一的面膜,它可是“全能型修复型选手”,一片可以解决多种肌肤问题,在补水、修复受训细胞、退色素、紧致方面尤为出色!

▲CCTV 2财经频道报道:品牌董事长喝面膜液
因为没有添加任何激素,安全高效,不少人给出了高度评价。成功引起了小编的好奇心,于是就买了一盒体验装。

想要获得明星同款补水面膜吗?
赶快添加黛汐魅高级护肤顾问
了解这款贵妇级平民价的
超滋润修复型的
素颜臻活面膜吧!

02
上脸不刺激,20分钟敷出水嫩少女肌
我用过几十款面膜,不得不说,这款“黛汐魅素颜面膜无论是使用感,还是效果,都丝毫不输RMB300/片的贵妇面膜。
贴上去特别的清爽,精华液不小心入眼,不会很刺激,就像水一样温和。才敷了半个月左右,我的脸蛋就像是喝饱了水一样“澎澎的”,肤色提亮了不少,因为皮肤亮了,“一白遮百丑”,毛孔和细纹也像隐形了一样。

闺蜜总打趣我:“敷了这面膜整张脸由内而外散发着雪花般晶莹剔透的质感,明明是同龄人,看着竟比我显年轻了。”这可真让我有点不好意思, 效果可真的是名不虚传啊!

最让小编感动的是
黛汐魅素颜臻活面膜精华真的超多,
整整30ml!
因为精华量足够多,
基本上敷一片就相当于
做了一次密集修护SPA!
剩下的记得要往脖子抹一抹哦。
我真的是一滴都不舍得浪费。

上脸不会很黏腻,超级清爽。
拿下来明显感觉皮肤细腻了很多,
整张脸水嫩嫩的。
特别好吸收,几乎不用按摩,
脸上的精华液哧溜一下都吸收进去了。
敷上15分钟都不会拔干。

最后让我们来看一下补水效果,
杠杠的!大拇指竖起。
保湿效果超赞!
坚持敷,上妆也会服帖不卡粉的。

03
膜布也高级,细节见匠心

太厚太薄的膜布都有用过,
使用感觉特别不舒爽。
如果有荧光剂简直不敢想象!
黛汐魅素颜臻活面膜就不一样。
它是天然环保安全的进口膜布,
仔细看上面是细软的茸毛。
轻!薄!透!

看看这织法的明显对比,
大家就明白了!
敷上脸温和柔软舒服。

更重要的是贴合脸型的裁剪,敷面膜再也不尴尬

它从元代“三庭五眼”吸取灵感,
按照亚洲人脸型裁切28稿。
最终得出现在的形状!
超超超贴合脸型,特别的服帖,
透气性很好。
敷上脸也不会闷闷哒!

用过黛汐魅家的面膜的姐妹们都表示,
真是越来越自信,重拾美丽和青春,
就算是素颜也敢出门了呢!
赶快添加黛汐魅高级护肤顾问,追寻美丽吧!

04
比起使用感受,攀越安全护肤新高度也很重要
长期混迹护肤界的姐妹都知道:各种荧光剂、防腐剂、铅汞等重金属所造成的严重后果,耸人听闻!特别对于使用率较高的面膜,违规添加导致的毁脸现象层出不穷。
小编仔细了解了一番黛汐魅素颜臻活面膜后,着实被TA的光环所迷住!
我还特地找了他们成分分类,其检测报告显示:不含香精、铅汞、激素、防腐剂和一切化学添加剂,多项安全指标超越国家标准近百倍,就连孕妇和重度敏感肌都能放心使用。

TA运用了多项前沿美肤科技,进行了数万次的效果和安全性测试,专家团队对待每一个细节,都如同对待艺术品一样极为挑剔和严苛。
而配合这片梦幻面膜的生产,兴建的高标准超级工厂,也足以体现黛汐魅素颜臻活面膜对纯粹无添加的执着和坚持。

专家指出:肌肤衰老的根本原因是缺水和肌底受损。而黛汐魅素颜臻活面膜之所以能延缓衰老,修复肌底细胞,其核心成分正是针对这两大原因而研发。
感受的到的补水,好像肌肤在一直喝个不停。它不仅能有效解决肌肤因缺水问题而产生的绝大部分问题。也能深入肌底促进胶原蛋白的形成,修复受损的孱弱肌底。

越来越多的女人拥有梦寐以求的“少女肌”
看看那些用过“黛汐魅素颜臻活面膜”
姐妹们的蜕变故事吧
![]()
![]()
![]()
???
“皱纹色斑,伤害的何止是脸蛋”
全职太太/42岁
咱女人就得活得优雅漂亮,让老公走到哪带到哪。
而半年前的我,皮肤暗黄,皱纹明显,满脸黄褐斑,连照镜子的自信都丧失了。而老公回家越来越晚,也越来越少带我出门,我就像是被打入冷宫的弃妇,整天自怨自艾,却又无可奈何!
直到遇见【黛汐魅素颜臻活面膜】,TA真的给了我太意外的惊喜!你看我现在的状态,肌肤白皙弹滑,就像喝饱水一样通透红润,不化妆也不会显得憔悴!

▲ 42 岁又怎样?依然可以美美哒
现在,老公大小聚会应酬,都强烈要求带着我出席,而自信优雅的我,瞬间秒杀一切太太团。觥筹交错中,自豪地传递着美容心得,心安理得接受太太们羡慕和憧憬的目光。
爱一个人,并不光是那个背后默默无闻的女人,还要成为他欣赏的女人。
“神奇!6 个月找回久违的自信”
阮慧/32 岁/外企白领
迫切等待?
传说中的无添加面膜已收到,迫不及待地体验。敷帖的感觉非常nice,清爽舒适,就连眼周沾满精华液,也没有丝毫刺激感。等精华液完全吸收后揭下,真的有被吓到,整个脸像小了一圈,当然是不可能真小,就是那种紧致上扬的感觉;其次,所敷到的地方,毛孔变细了,皮肤水水嫩嫩的,带着好心情美美地睡去。

惊喜不断?
早上梳妆完毕,看到皮肤状态仍旧很惊喜,大毛孔还没有暴露,脸蛋摸起来又软又滑,修复功能杠杠的,完全超出我的期待,单是持久度这一点我给99分!我会继续回购,如果多一些优惠就给满分......

完美蜕变?
几乎每一天都能感觉肌肤的蜕变新生,坚持用了一段时间后,原来的痘印和粗毛孔明显改善。那种紧致嫩滑、白皙通透,仿佛又回到10年前的自己,多年未见的老同学都说我还是学生时代的模样。如今,我又迷上了自拍,不用美颜相机,我也能很自信地跟朋友分享我的照片。


给脸蛋细致的呵护,并非我们自认花瓶,只是我们希望活得更好,老得慢一点,老得优雅体面一点。
时间带给我们的,应该是数若珍宝的回忆,而不是一根根白发,一条条细纹带来的恐慌。当你的外在美好而富于条理,事业、爱情、友情都会为你锦上添花!
归结到底,女人还是一定要对自己好点,舍得投资自己,保养自己,在岁月的磨砺中活成自己想要的模样。
既然有能力,为什么不给自己最好的呵护呢?
马上扫描二维码添加黛汐魅高级护肤顾问的微信,
美丽在等你,时间不会给你机会。
莫犹豫↓↓↓